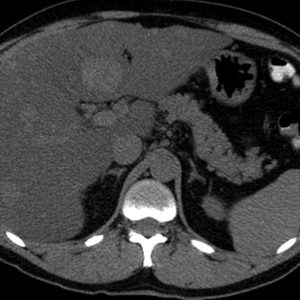
Di căn gan

TIÊU HOÁ
Hiển thị 1221–1240 của 1445 kết quảĐã sắp xếp theo mới nhất
-

Túi mật đôi
Lượt xem: 246» 12-11-2018 -

Túi thừa đại tràng
Lượt xem: 133» 12-11-2018 -

Hội chứng Boerhaave
Lượt xem: 201» 11-11-2018 -

Túi thừa đại tràng
Lượt xem: 145» 10-11-2018 -

Lao gan
Lượt xem: 295» 10-11-2018 -

Lymphoma gan
Lượt xem: 142» 10-11-2018 -

Huyết khối tĩnh mạch cửa
Lượt xem: 488» 10-11-2018 -

Di căn gan
Lượt xem: 126» 10-11-2018 -

Di căn gan
Lượt xem: 119» 10-11-2018 -

Di căn gan
Lượt xem: 147» 10-11-2018 -

Di căn gan
Lượt xem: 155» 10-11-2018 -

Di căn gan
Lượt xem: 156» 10-11-2018 -

Di căn gan
Lượt xem: 132» 10-11-2018 -

Di căn gan
Lượt xem: 136» 10-11-2018 -

Di căn gan
Lượt xem: 135» 10-11-2018 -

Di căn gan
Lượt xem: 145» 10-11-2018 -

Di căn gan
Lượt xem: 140» 10-11-2018 -

Di căn gan
Lượt xem: 129» 10-11-2018 -

Di căn gan
Lượt xem: 143» 10-11-2018 -

Di căn gan
Lượt xem: 145» 10-11-2018